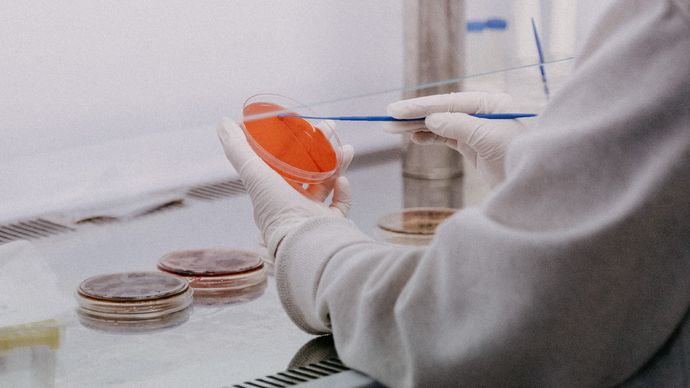
الجمعية الوطنية للتصلب المتعدد تمنح تمويلا لستة مشروعات مبتكرة في الدولة

الأربعاء 24 يناير 2024 03:34 مساءً - متابعة – نغم حسن
أعلنت الجمعية الوطنية للتصلب المتعدد في دولة الإمارات، عن تمويلها منحا بحثية لستة مشاريع مبتكرة، بالتعاون مع دائرة الصحة – أبوظبي، وفي إطار التزامها بقيادة جهود البحث والتطوير التي تصب في إيجاد علاج للتصلب المتعدد.
وبحسب “وام”، تلقت الجمعية، 12 طلبا استجابة لمبادرتها، وأعلنت عن الفائزين بالمنح البحثية التي ناقشت مواضيع متعددة مثل LAMINATE التي تعتبر أداة تجزئة آفات وضمور التصلب المتعدد الطولية القائمة على الذكاء الاصطناعي مقدم من جامعة نيويورك – أبوظبي.
وقدم هارلي ستريت ميديكال سنتر، بحثاً عن التصلب المتعدد عند الأطفال وعلم الأوبئة والخصائص السريرية وأنماط العلاج في منطقة الشرق الأوسط وشمال أفريقيا.
أما بخصوص التشخيص المبكر والدقيق في الوقت المناسب للتصلب المتعدد من البيانات متعددة الوسائط باستخدام الذكاء الاصطناعي، فقد فازت جامعة محمد بن زايد للذكاء الاصطناعي بمنحة لمشروعها البحثي في هذا الموضوع، وفازت كليفلاند كلينيك أبوظبي بمنحتين لمشروعيها عن علم الأوبئة على مستوى الدولة لمرض التصلب المتعدد في دولة الإمارات، وأهلية التصعيد مقابل النهج المكثف المبكر للمتعايشين مع التصلب المتعدد التقدمي الانتكاسي باستخدام التصوير بالرنين المغناطيسي، وفي مجال التجارب السريرية، فاز مركز أبوظبي للخلايا الجذعية بمنحة عن دراسة عشوائية مضبوطة حول تقييم سلامة وفعالية العلاج الضوئي المناعي (ECP) في علاج التصلب المتعدد (دراسة PHOMS).
وقالت سعادة الدكتورة فاطمة الكعبي نائب رئيس مجلس أمناء الجمعية الوطنية لمرض التصلب المتعدد في دولة الإمارات والمدير التنفيذي لبرنامج زراعة نخاع العظم (AD-BMT©) في مركز أبوظبي للخلايا الجذعية: نفخر بدعم وتمويل ستة مشاريع بحثية حول علاجات وتشخيص وخصائص التصلب المتعدد في دولة الإمارات العربية المتحدة، حيث تم اختيار هذه المشاريع بعناية بالنظر إلى أهميتها ومواءمتها مع أهداف وأولويات الجمعية الوطنية للتصلب المتعدد، والتي تقدم فهماً أعمق حول انتشار التصلب المتعدد في الدولة كما تساهم في تعزيز المعرفة العلمية الشاملة التي تمكننا من تطوير تقنيات التشخيص وخيارات العلاج في الدولة وربما في جميع أنحاء العالم.
وأضافت: تلقينا 12 طلباً استجابةً لإعلاننا عن المبادرة الأمر الذي يشير إلى الاهتمام المحلي والإقليمي بإجراء الأبحاث حول التصلب المتعدد في الدولة ويؤكد على التزام الجمعية بتوفير الدعم والموارد والتعاون مع المؤسسات الإقليمية التي تشارك الجمعية نفس الرؤية.
بدورها، قالت الدكتورة أسماء المناعي المدير التنفيذي لمركز الأبحاث والابتكار في دائرة الصحة – أبوظبي: تعمل الدائرة على قيادة ودعم كل الجهود البحثية الرامية إلى تقديم أفضل الخدمات العلاجية والعلاجات المبتكرة لأفراد المجتمع في أبوظبي والعالم؛ ومن خلال عملنا مع الجمعية الوطنية للتصلب المتعدد، نمضي بجهودنا لاستكشاف وإيجاد حلول مبتكرة جديدة للأمراض النادرة والمستعصية مثل التصلب المتعدد بما يجسد حرصنا على ترسيخ مكانة أبوظبي كوجهة رائدة في مجال الرعاية الصحية وحاضنة للبحث والابتكار في علوم الحياة، ونتطلع إلى رؤية النتائج الواعدة التي سيحققها الباحثون الملهمون في تشخيص وعلاج مرض التصلب المتعدد.



